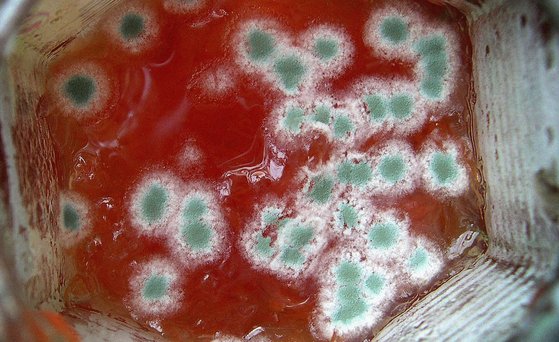
Grüner Schimmelpilz.

Biocidal product types
Based on their intended use, biocidal products are subdivided into four main groups in accordance with Annex V of Biocidal Product Regulation (EU) No 528/2012: Disinfectants, preservatives, pest control and other biocidal products.
Main group 1: Disinfectants
Disinfectants are used in private, public or industrial areas for the disinfection of air, water (e.g. swimming pools, aquariums, bathing waters), surfaces, materials, equipment and furniture.
For the food and feed area, products are used for the disinfection of equipment, containers, consumption utensils, surfaces and pipework associated with the production, transport, storage or consumption of food, feed or drinks (including drinking water) for humans and animals.
Common active biocidal substances in disinfectants are isopropanol, n-propanol, ethanol and quaternary (from Latin quaternarius = of four each) ammonium compounds.
Resistance and skin damage from improper use of disinfectants
Disinfectants must always be used in accordance with the information in the instruction manual. Improper use can lead to the development of resistance in the target organisms. In this case, the disinfectants are either not very effective or no longer effective at all.
The habitual use of disinfectants in private areas can also lead to skin damage.
Product types in main group 1 of biocidal products: "Disinfectants"
Product type 1: Human hygiene
Product type 2: Disinfectants and algaecides that are not intended for direct application to humans or animals
Product type 3: Veterinary hygiene
Product type 4: Food and feed area
Product type 5: Drinking water
These products exclude cleaning products that are not intended to have a biocidal effect, including washing liquids, washing powders and similar products
Main group 2: Preservatives
These products are used to protect products against harmful organisms.
Unless otherwise stated, these product types only include products to prevent microbial and algal development.
Product types in main group 2 of biocidal products: "Preservatives"
Product type 6: Preservatives for products during storage
Product type 7: Film preservatives
Product type 8: Wood preservatives
Product type 9: Fibre, leather, rubber and polymerised materials preservatives
Product type 10: Construction material preservatives
Product type 11: Preservatives for liquid-cooling and processing systems
Product type 12: Slimicides
Product type 13: Working or cutting fluid preservatives
Main group 3: Pest control
These product types are used to control and prevent harmful organisms and pests (mice, rats and other rodents; insects, articulates, worms etc.).
German Infection Protection Act (IfSG)
Pest control is currently regulated by the German Infection Protection Act in addition to Biocide Regulation (EU) No 528/2012. This stipulates that only agents and methods that have been recognised by the competent higher federal authority (in this case the Federal Environment Agency) may be used within the framework of official pest control in accordance with Section 18 of the Infection Protection Act. The competent higher federal authority keeps a list of the respective recognised agents and methods and publishes it. The BfRshort forGerman Federal Institute for Risk Assessment is involved in the health assessment of the agents.
Product types in main group 3 of biocidal products: "Pest control"
Product type 14: Rodenticides
Product type 15: Avicides
Product type 16: Molluscicides, vermicides and products to control other invertebrates
Product type 17: Piscicides
Product type 18: Insecticides, acaricides and products to control other arthropods
Product type 19: Repellents and attractants
Product type 20: Control of other vertebrates
The approval and use of products to control birds (product type 15) and fish (product type 17) are not provided for in Germany for reasons of animal welfare.
Main group 4: Other biocidal products
Product types in main group 4: "Other biocidal products"
Product type 21: Antifouling products
Product type 22: Embalming and taxidermist fluids